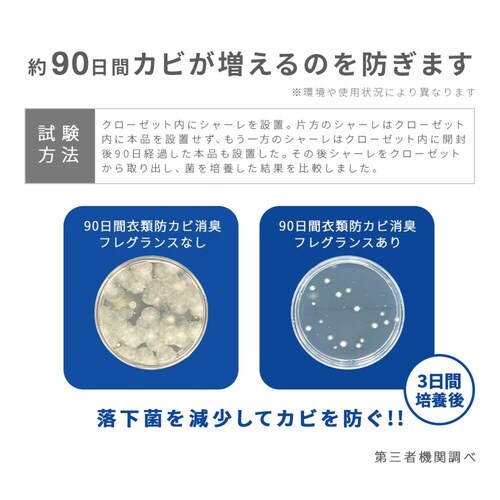
芳香剤 90日間 衣類 防カビ 消臭 フレグランス

アイメディア
芳香剤 90日間 衣類 防カビ 消臭 フレグランス クローゼット用 自然由来 ※3個以上から注文可能(販売価格は1個単位の価格)
【9284-3004】



| ¥1,100 (税込) / ¥1,000 (税抜) |
| ¥1,100 (税込) / ¥1,000 (税抜) |
| メーカー希望小売価格 オープン |
|---|
消臭剤(靴箱・クローゼット用)の売れ筋ランキング
- ¥275(税込) (税込) 〜
- ¥396(税込) (税込) 〜
- ¥522(税込) (税込)
- ¥1,188(税込) (税込)
- ¥539(税込) (税込)
- ¥539(税込) (税込)
- ¥539(税込) (税込)
商品の特徴 |
24時間ほのかに香り、カビから守って消臭してくれるクローゼット用芳香剤です。 置くだけゲルタイプなので設置も簡単です。 グリーンミントの香りです。 約90日間、効果が持続します。 |
|---|---|
商品仕様 |
|
メーカー情報 |
|
カタログ掲載ページ |
-/- |
| 注意事項 | ※使用目安:クローゼット800から2400Lに1個 |
|---|